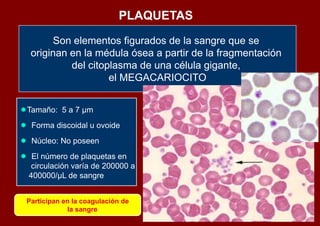
PLAQUETAS

       Son elementos figurados de la sangre que se
  originan en la médula ósea a partir de la fragmentación
           del citoplasma de una célula gigante,
                    el MEGACARIOCITO


Tamaño: 5 a 7 µm
 Forma discoidal u ovoide
 Núcleo: No poseen
 El número de plaquetas en
  circulación varía de 200000 a
 400000/µL de sangre


 Participan en la coagulación de
             la sangre

Este documento describe el tejido sanguíneo. Explica que la sangre está compuesta de células y plasma. Las células incluyen eritrocitos, leucocitos como neutrófilos y linfocitos, y plaquetas. El plasma transporta gases, nutrientes, hormonas y desechos. También describe cómo se prepara un frotis sanguíneo para estudiar las células bajo el microscopio usando colorantes.